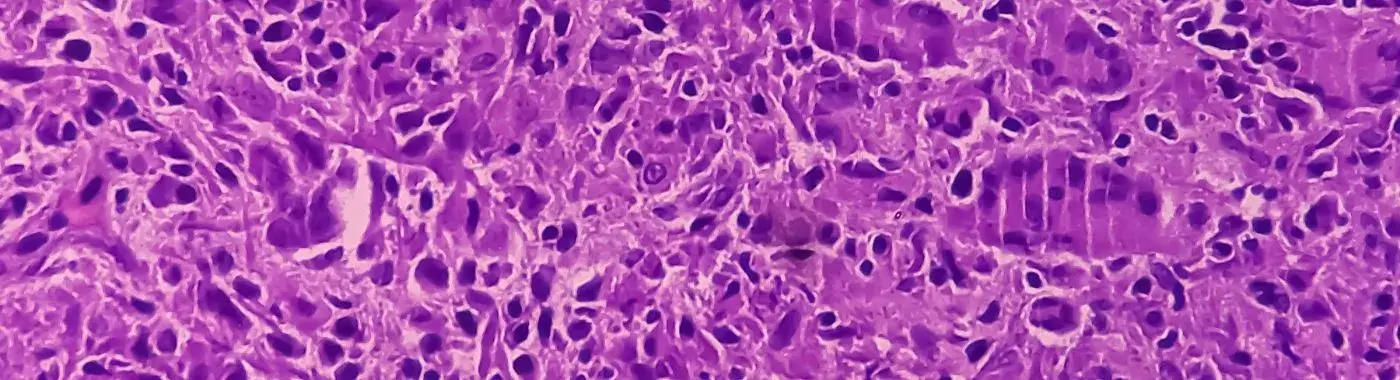
Chronic Granulomatous Disease - Causes, Symptoms, Diagnosis, Treatment, and Prevention

- Diseases and Conditions
- Chronic Granulomatous Disease - Causes, Symptoms, Diagnosis, Treatment, and Prevention
Chronic Granulomatous Disease - Causes, Symptoms, Diagnosis, Treatment, and Prevention
Chronic Granulomatous Disease: Understanding a Rare Immunodeficiency
Introduction
Chronic Granulomatous Disease (CGD) is a rare genetic disorder that affects the immune system, making individuals more susceptible to infections. This condition is significant not only because of its impact on health but also due to the challenges it presents in diagnosis and management. Understanding CGD is crucial for patients, families, and healthcare providers to ensure timely intervention and effective treatment.
Definition
Chronic Granulomatous Disease is a hereditary immunodeficiency disorder characterized by the inability of certain white blood cells, known as phagocytes, to effectively kill certain types of bacteria and fungi. This defect leads to the formation of granulomas—clusters of immune cells that form in response to chronic inflammation. These granulomas can cause various complications, affecting multiple organs and systems in the body.
Causes and Risk Factors
Infectious/Environmental Causes
While CGD is primarily a genetic disorder, individuals with this condition are at increased risk for infections caused by specific organisms, particularly catalase-positive bacteria and fungi. These include:
- Staphylococcus aureus
- Aspergillus species
- Serratia marcescens
- Nocardia species
Environmental factors, such as exposure to certain pathogens, can exacerbate the risk of infections in individuals with CGD.
Genetic/Autoimmune Causes
CGD is most commonly caused by mutations in genes that encode components of the NADPH oxidase complex, which is essential for the production of reactive oxygen species (ROS) used by phagocytes to kill pathogens. The most common forms of CGD are:
- X-linked CGD: Caused by mutations in the CYBB gene on the X chromosome, affecting primarily males.
- Autosomal recessive CGD: Caused by mutations in one of several other genes (e.g., NCF1, NCF2, CYBA) and can affect both males and females.
Lifestyle and Dietary Factors
While lifestyle and dietary factors do not directly cause CGD, maintaining a healthy lifestyle can help manage the condition. A balanced diet rich in vitamins and minerals can support overall immune function, while avoiding known allergens and irritants can reduce the risk of infections.
Key Risk Factors
- Age: CGD is usually diagnosed in childhood, but symptoms can appear at any age.
- Gender: Males are more frequently affected due to the X-linked inheritance pattern of the most common form.
- Geographic Location: Certain populations may have a higher prevalence of CGD due to genetic factors.
- Underlying Conditions: Individuals with other immune deficiencies may be at increased risk for infections.
Symptoms
The symptoms of Chronic Granulomatous Disease can vary widely among individuals but commonly include:
- Frequent infections: Recurrent bacterial and fungal infections, particularly in the lungs, skin, and lymph nodes.
- Granulomas: Chronic inflammation leading to the formation of granulomas, which can cause obstruction in various organs.
- Fever: Persistent or recurrent fevers due to infections.
- Fatigue: Generalized weakness and fatigue from chronic infections.
- Skin lesions: Abscesses or other skin infections that are slow to heal.
Warning Signs
Immediate medical attention should be sought if an individual with CGD experiences:
- High fever that does not respond to treatment.
- Severe abdominal pain or swelling.
- Difficulty breathing or persistent cough.
- Signs of severe skin infections or abscesses.
Diagnosis
Clinical Evaluation
The diagnosis of Chronic Granulomatous Disease begins with a thorough clinical evaluation, including:
- Patient History: A detailed history of recurrent infections, family history of immunodeficiency, and any previous medical issues.
- Physical Examination: Assessment for signs of infections, granulomas, and other related symptoms.
Diagnostic Tests
Several tests are used to confirm a diagnosis of CGD:
- Nitroblue Tetrazolium (NBT) Test: Measures the ability of phagocytes to produce reactive oxygen species.
- Dihydrorhodamine (DHR) Test: A more sensitive test that assesses the oxidative burst of phagocytes.
- Genetic Testing: Identifies specific mutations in the genes associated with CGD.
Differential Diagnosis
Other conditions that may present with similar symptoms include:
- Other forms of immunodeficiency (e.g., Hyper-IgE syndrome).
- Autoimmune diseases.
- Chronic infections.
Treatment Options
Medical Treatments
Management of Chronic Granulomatous Disease typically involves:
- Antibiotics and Antifungals: Prophylactic antibiotics and antifungal medications to prevent infections.
- Interferon-gamma: This medication can enhance the immune response and reduce the frequency of infections.
- Corticosteroids: Used to manage inflammation caused by granulomas.
In severe cases, bone marrow transplantation may be considered as a curative option.
Non-Pharmacological Treatments
Lifestyle modifications can play a crucial role in managing CGD:
- Dietary Changes: A balanced diet rich in antioxidants may help support immune function.
- Hygiene Practices: Regular handwashing and avoiding contact with sick individuals can reduce infection risk.
- Vaccinations: Staying up-to-date with vaccinations, particularly for preventable diseases, is essential.
Special Considerations
- Pediatric Patients: Early diagnosis and management are critical to prevent complications.
- Geriatric Patients: Older adults may have different responses to treatment and may require tailored management strategies.
Complications
If left untreated or poorly managed, Chronic Granulomatous Disease can lead to several complications:
Short-Term Complications
- Severe Infections: Life-threatening infections that can lead to hospitalization.
- Abscess Formation: Infections can lead to the formation of abscesses in various organs.
Long-Term Complications
- Organ Damage: Chronic inflammation and granuloma formation can lead to damage in organs such as the lungs, liver, and intestines.
- Increased Cancer Risk: Individuals with CGD may have a higher risk of developing certain types of cancer, particularly lymphomas.
Prevention
While CGD cannot be prevented due to its genetic nature, certain strategies can help reduce the risk of infections:
- Vaccinations: Ensure vaccinations are up-to-date, particularly for pneumococcal and influenza vaccines.
- Hygiene Practices: Regular handwashing and avoiding crowded places during outbreaks can help prevent infections.
- Dietary Modifications: A diet rich in fruits, vegetables, and whole grains can support overall health.
Prognosis & Long-Term Outlook
The prognosis for individuals with Chronic Granulomatous Disease varies based on several factors, including:
- Early Diagnosis: Early identification and management can significantly improve outcomes.
- Adherence to Treatment: Consistent use of prophylactic medications and regular medical follow-ups are crucial for managing the disease.
With appropriate care, many individuals with CGD can lead relatively normal lives, although they may require ongoing medical supervision.
Frequently Asked Questions (FAQs)
- What is Chronic Granulomatous Disease?
Chronic Granulomatous Disease is a genetic disorder that affects the immune system, making it difficult for the body to fight off certain infections. It is characterized by the formation of granulomas due to chronic inflammation. - What causes CGD?
CGD is caused by mutations in genes responsible for the production of reactive oxygen species in phagocytes, leading to an impaired immune response against certain bacteria and fungi. - What are the symptoms of CGD?
Common symptoms include frequent infections, granuloma formation, fever, fatigue, and skin lesions. Symptoms can vary widely among individuals. - How is CGD diagnosed?
Diagnosis involves a clinical evaluation, including patient history and physical examination, along with specific tests like the NBT test, DHR test, and genetic testing. - What treatments are available for CGD?
Treatment options include prophylactic antibiotics, antifungals, interferon-gamma, and in severe cases, bone marrow transplantation. - Can CGD be cured?
While there is no cure for CGD, effective management strategies can help control symptoms and reduce the risk of infections. Bone marrow transplantation may offer a potential cure for some patients. - What lifestyle changes can help manage CGD?
Maintaining good hygiene, following a balanced diet, and staying up-to-date with vaccinations can help manage CGD and reduce infection risk. - Are there any complications associated with CGD?
Yes, complications can include severe infections, organ damage due to granulomas, and an increased risk of certain cancers. - What is the long-term outlook for individuals with CGD?
With proper management, many individuals with CGD can lead normal lives, although they may require ongoing medical supervision and treatment. - When should I seek medical help for CGD?
Seek immediate medical attention if you experience high fever, severe abdominal pain, difficulty breathing, or signs of severe skin infections.
When to See a Doctor
Individuals with Chronic Granulomatous Disease should seek immediate medical attention if they experience:
- Persistent high fever.
- Severe abdominal pain or swelling.
- Difficulty breathing or persistent cough.
- Signs of severe skin infections or abscesses.
Conclusion & Disclaimer
Chronic Granulomatous Disease is a complex condition that requires careful management and understanding. By recognizing the symptoms, seeking timely medical care, and adhering to treatment plans, individuals with CGD can lead fulfilling lives. This article serves as an informational resource and should not replace professional medical advice. Always consult a healthcare provider for personalized guidance and treatment options.


 Best Hospital Near me Chennai
Best Hospital Near me Chennai

